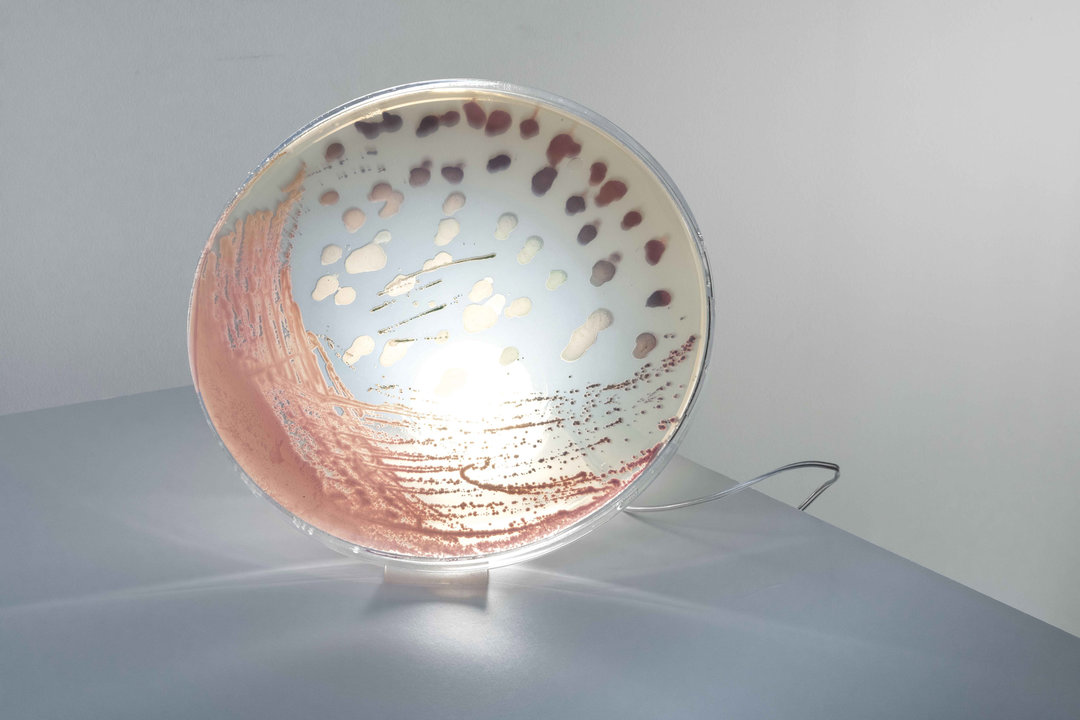
雷克萨斯联名款,雷克萨斯耐克

「这个设计了不起」的微信公众号上线啦,直接搜索「BestDesign」或是「Qthings」就可以订阅,关注我们每日发现的新鲜好设计。
Lexus “Sole of the UX” Tires
如今在球鞋圈和潮流圈,联名已经屡见不鲜。但汽车品牌的联名却还是罕见的新玩法。最近,汽车品牌雷克萨斯也玩起了联名,与 John Elliott 合作,带来一款以 Air Force 1 为灵感的球鞋轮胎。
John Elliott 曾经与 Nike 多次合作,推出过 LeBron Icon 以及联名版 Air Force 1。
这次与 Lexus 的合作就以 Air Force 1 为灵感,选用最经典的纯白色调打造轮胎。其防滑纹理融入了 Swoosh Logo、“AIR” 文字以及其他鞋身设计元素。







Noctambule by Konstantin Grcic for Flos
在不久前的 2019 斯德哥尔摩家具灯饰展上,意大利灯具品牌 Flos 向斯堪的纳维亚市场展出了一系列建筑照明系统以及家居系列的全新产品。今年,Flos 展台由多面色彩柔和的墙壁组成,为适应产品提供了精致的背景,其中包含与 Konstantin Grcic、Michael Anastassiades 以及 Nendo 等知名设计师的合作作品。
Konstantin Grcic 的合作项目 Noctambule(梦游),其最显著特征莫过于透明玻璃的圆柱形态。这一系列包含透明玻璃材质的模块可以互相堆叠,创造出落地灯或吊灯,还可以加入玻璃圆顶或锥形灯头进行补充。




DIY wheelchair by Apichai Inthutsingh
DIY 轮椅是一款用二手购物车制作的轮椅,可以成为无法负担普通轮椅价格的肢体残疾人士、老人或病人的辅助工具。
设计师 Apichai Inthutsingh 想要帮助尽可能多的人,希望借助此次的设计向人们展示如何改造普通购物车,并将其改造为适合自身生活方式的轮椅。
Apichai Inthutsingh 研究了两种不同设计,分别是为不需看护人的使用者设计的“手动推进式轮椅”,自推进能力成为关键元素。另一款“运输轮椅”则由一位家庭成员或护理者推动,具有质量轻且容易移动的特点,最终成品也是这一款,只需对二手购物车进行简单调整,加入提升舒适度的小篮子、软垫以及手刹等零件便可完成。








Bacteria Lamps by Jan Klingler
这款名为 Bacteria 的灯具,出自设计师 Jan Klingler 之手。这是 斯德哥尔摩 ArkDes 青年瑞典设计展的一部分,用在树脂板上种植的细菌培养物,装饰 LED 灯制作而成。
它有两个版本,一个是可以挂在墙上的圆形灯,一个是容易让人联想到实验室烧杯的台灯,但两个灯的核心元素都是一个颜色明丽的细菌盘。
这款新作融合了 Jan Klingler 对工业设计和微生物学的兴趣。“我希望美学能够受到实验室工作的启发,通常当你在实验室培养皿中培养细菌时,我想让它变得非常抽象,但仍然让人想起实验室,”他表示。
为了创造独特的斑点设计,Jan Klingler 收集细菌、酵母和真菌,让它们在树脂盘上生长 24 到 48 小时。然后,设计师将树脂板连接到 LED 盘或一组 LED 模块,这些 LED 模块通过细菌培养物发光以提供光源。

ToP (Tarp on PET) by FREITAG
瑞士环保设计品牌 FREITAG 最近发布了全新 ToP(Tarp on PET)系列,主打最轻的新包款。除了延续其标志性的卡车防水布料之外,还结合了回收再生 PET 加工而成的纺织材料,打造柔韧与轻巧兼具的特点。
整个系列包括四款,分别为 F610 CINNAMON 多功能抽绳包、F600 CARTER 通勤背包、F640 ROLLIN 卷盖式跨肩背包、F645 PHELPS 带有隐藏式卡车防水布的斜背包。除了第一款CINNAMON 之外,其它三款将于 3 月 14 日上架于 FREITAG 门店、指定零售商以及官方网站。




